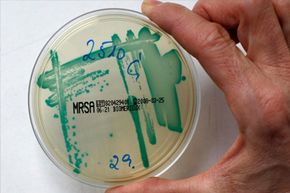
Can Antibiotic-Resistant Bacteria Lose Their Resistance?

In the modern world, we've come to depend upon antibiotics to rescue us from scary diseases that range from syphilis to leprosy. But one thing that really frightens doctors and public health professionals is the possibility that some of our most important antibiotics may stop working as bacteria develop resistance to them.
Unfortunately, that nightmare already is becoming a reality. A 2014 study by the World Health Organization (WHO) found high rates of antibiotic resistance among common bacteria ranging from E. coli to Staphylococcus aureus and reported that patients with drug-resistant infections in some cases are twice as likely to die. "The problem is so serious that it threatens the achievements of modern medicine," the report concluded. "A post-antibiotic era -- in which common infections and minor injuries can kill -- is a very real possibility for the 21st century" [source: WHO].
Antibiotic resistance is a result of the same basic evolutionary process that gave humans big brains and enabled us to walk upon two legs instead of dragging our knuckles on the ground. When a patient takes an antibiotic to fight a bacterial infection, the bacteria whose genetic makeup makes them susceptible to the drug are killed off or damaged. But not all of the bacteria die or become fatally weakened. That creates what geneticists call "selective pressure" for the survival of resistant strains of bacteria. Some may develop spontaneous mutations that produce enzymes that deactivate antibiotics, or else close up the entry ports that allow antibiotics into a cell. Bacteria can use viruses to transfer their drug-resistant genes from one individual to another. So once one bacterium is resistant, others quickly can join the club [source: APUA].
The good news: Bacteria can also lose their resistance to antibiotics, as well. Genetics has a sort of "use it or lose it" principle. When the selective pressure that encourages the mutations to spread is eliminated, it's possible for a bacterial population to revert to its former state of vulnerability [source: APUA].
Unfortunately, this reversal process occurs more slowly than the creation of the resistance [source: APUA]. So we probably can't depend upon it to save us from antibiotic-resistant diseases. Instead, we're better off limiting our use of antibiotics to only when it's necessary.